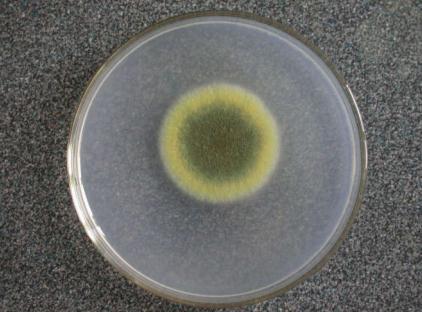
真菌检测的方法都有哪些?

1、真菌镜检
是最简单也是很有价值的实验室诊断方法。其优点在于简便、快速,无菌部位的阳性结果可直接确定真菌感染。但是由于阳性率较低,阴性结果亦不能排除诊断。直接镜检对于浅表和皮下真菌感染最有帮助。

2、真菌培养
真菌培养是实验室检查中的重要环节,培养出致病真菌是进一步鉴定菌种的前提条件。常规的真菌培养需要在28-30°C温度下培养3-4 周,一般培养选用沙氏培养基(SDA)或者马铃薯琼脂培养基(PDA)。
3、分子生物学鉴定
常用的分子生物学鉴定方法包括:真菌DNA 硷基组成(G+C Mol%)、限制性片段长度多态性(RFLP)、随机扩增多态性DNA(RAPD)、Southern 印迹、脉冲场凝胶电泳(PFGE)、rDNA序列测定等。 4、生理学和生物化学方法
在纯培养上真菌生长比较快,可用生理、生化方法来鉴定菌种,多用于酵母菌鉴定。对碳水化合物的利用能力是酵母菌鉴定的主要手段,真菌生长温度试验也用于鉴定。目前API系统,可用于丝状真菌的辅助鉴定。此外,微生物自动鉴定系统Vitek、autoSCAN-4、Biolog和MIS等自动鉴定系统,可较满意地鉴定临床上常见病原性酵母菌。
5、血清学方法检测真菌抗原成分
(1)β-D-1,3葡聚糖(BDG):是许多真菌细胞壁的主要成份,如念珠菌、曲霉、镰刀菌等,但不包括隐球菌和接合菌;由于细菌、病毒、哺乳动物无这种成份,因而在循环血液中测得时则提示侵袭性真菌感染,目前已经有商品化BDG检测的试剂盒。
(2)半乳甘露聚糖(GM):GM是存在于曲霉和青霉细胞壁的一种热稳定的多糖,可用于侵袭性曲霉病的临床诊断。使用血清和支气管肺泡灌洗液可检测 GM,近来也有人使用尿液和脑脊液等标本检测。GM检测的敏感性为29-100%,而其特异性可超过90%。由于GM量的多少与组织中真菌含量密切相关, 因此检测GM还可以提示疾病的预后。